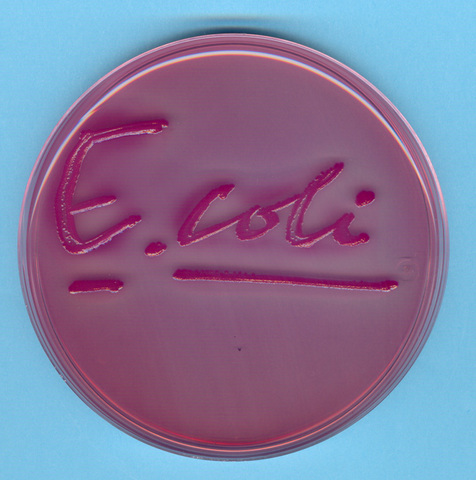
Descubren el E. Coli

-
Francesco Redi fue el primero en refutar la teoría de la generación espontánea en gusanos.
-
Anton van Leeuwenhoek es el primero en observar bacterias
-
Edward Jenner desarrolla la primera vacuna contra la viruela humana.
-
Miles Joseph Berkeley descubre un hongo (Phytophthora infestans) que produce la podredumbre de la patata.
-
John Snow demostró que el cólera era causado por el consumo de aguas contaminadas con materias fecales
-
Friederich Miescher descubre el ADN en el esperma de trucha.
-
Robert Koch demuestra que el carbunco o ántrax es causado por Bacillus anthracis
-
Carlos Finlay observa que la fiebre amarilla es transmitida por mosquitos.
-
Robert Koch descubre el Mycobacterium tuberculosis
-
Christian Gram desarrollo la tinción de Gram.
-
Elias metchnikoff En 1884 formuló la "teoría fagocitósica de la inmunidad", que explicaría la capacidad del cuerpo humano para resistir y vencer las enfermedades infecciosas.
-
Robert Koch publica sus Postulados.
-
Louis Pasteur puso a punto una vacuna contra la rabia.
-
Escherich descubre Escherichia coli.
-
Richard Petri introduce el uso de las placas Petri en Microbiología.
-
Dimitri Ivanovski demuestra que el mosaico del tabaco es producido por un virus.
-
Fritz Schaudinn y Erich Hoffmann demuestran que el Treponema pálidum es el agente productor de la sífilis.
-
Paul Ehrlich descubre el salvarsán, primer agente quimioterapéutico contra la sífilis.
-
Francis Peyton Rous descubre el virus que produce sarcomas en pollos.
-
Frederick Twort descubre los virus que infectan bacterias (bacteriófagos)
-
Félix d'Herelle descubre más virus bacteriófagos.
-
se publica por primera vez el Manual Bergey de Microbiología.
-
Frederick Griffith lleva a cabo el descubrimiento de la transformación bacteriana
-
Alexander Fleming aísla la penicilina de un cultivo de Penicillium notatum.
-
Helmut Ruska inventa el microscopio electrónico.
-
Frits Zernike desarrolla el microscopio de contraste de fases que permite ver microorganismos vivos.
-
Domagk descubre las sulfamidas, el primer agente quimioterapeútico
-
Wendell Meredith Stanley consigue cristalizar el virus del mosaico del tabaco
-
Oswald Avery, Colin MacLeod y Maclyn McCarty demuestran que el ADN es el material genético.
-
James D. Watson y Francis Crick consiguen dilucidar la estructura en doble hélice del ADN
-
Werner Arber, Daniel Nathans y Hamilton Smith descubren los enzimas de restricción, herramientas esenciales para el desarrollo de la Ingeniería Genética.
-
Woese y George E. Fox reconocen las archeas como el tercer dominio de los seres vivos.
-
Frederick Sanger desarrolla el método de los dideoxinucleótidos para la secuenciación del ADN
-
La viruela fue declarada oficialmente erradicada
-
se produce insulina humana usando bacterias Escherichia coli mediante técnicas de ingeniería genética. Se comercializó en 1982.
-
Willy Burgdorfer Es conocido por el descubrimiento en 1981 de la espiroqueta Borrelia burgdorferi, la bacteria causante de una enfermedad llamada Borreliosis de Lyme
-
Descubrimiento del VIH por Luc Montaigner y robert gallo
-
Clements y Bullivant descubren Epulopiscium fishelsoni, la mayor célula procariota
-
fue descubierta por Heide H. Schulz en 1999, en la costa de Namibia.
-
descubrimiento del proceso de esporulacion del mycobacterium
Plan projects on a visual timeline
Map milestones, phases, deadlines, and key events in one place so the sequence is easier to see and share. Timetoast is a timeline maker for work, school, research, and stories.